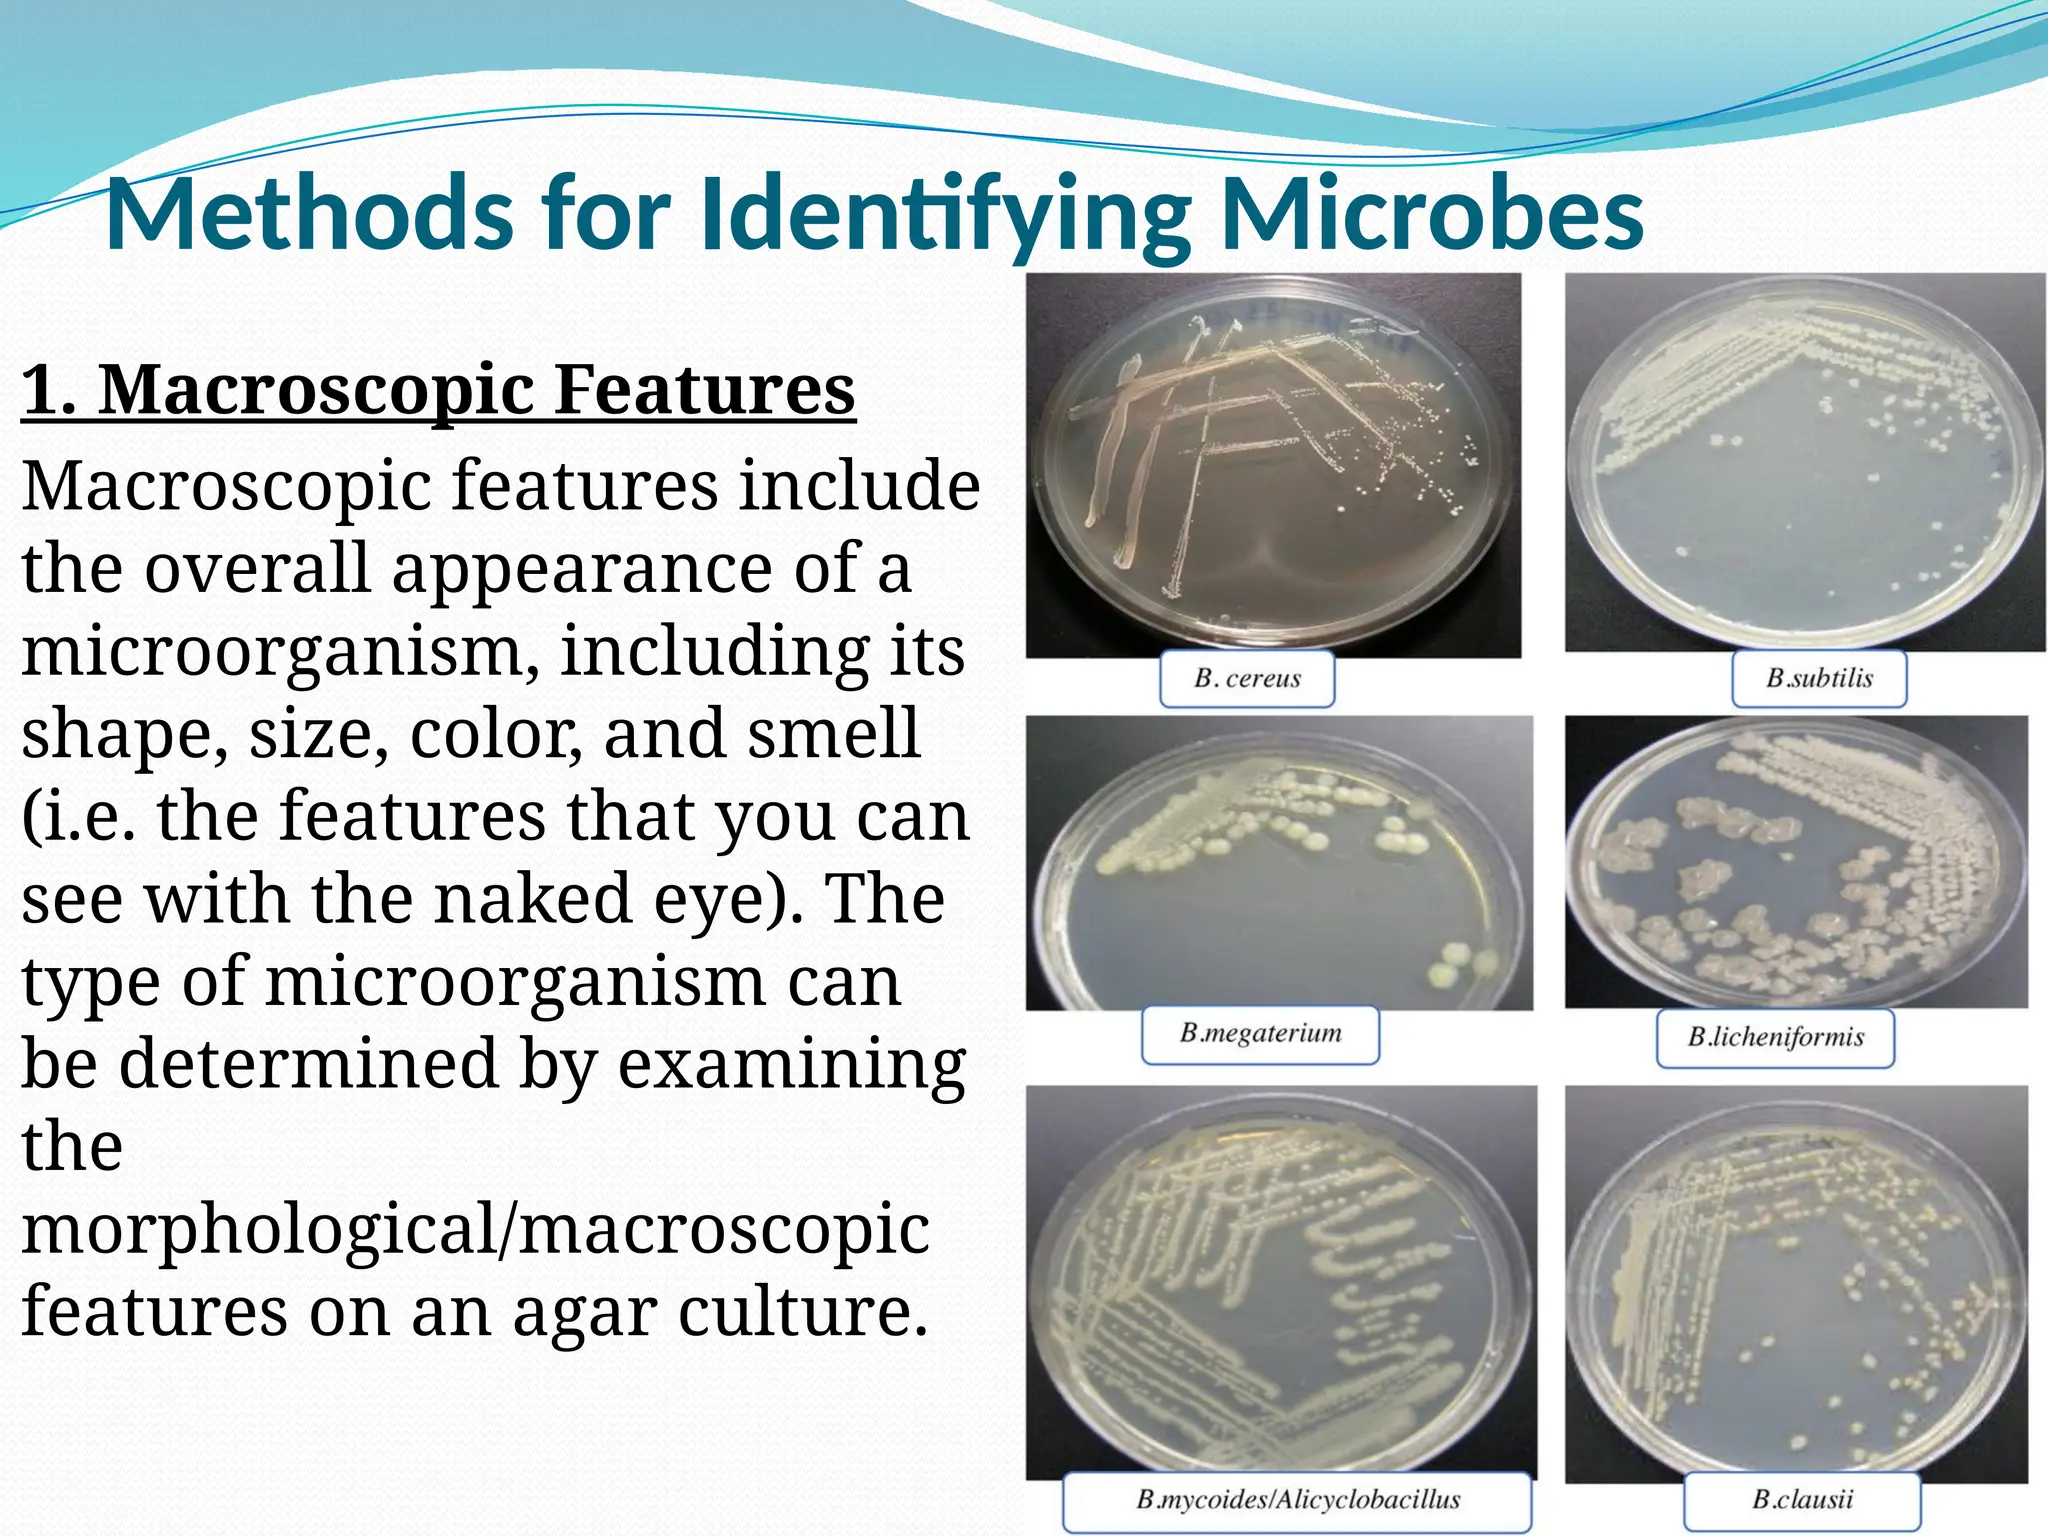
Methods for Identifying Microbes
1. Macroscopic Features
Macroscopic features include
the overall appearance of a
microorganism, including its
shape, size, color, and smell
(i.e. the features that you can
see with the naked eye). The
type of microorganism can
be determined by examining
the
morphological/macroscopic
features on an agar culture.
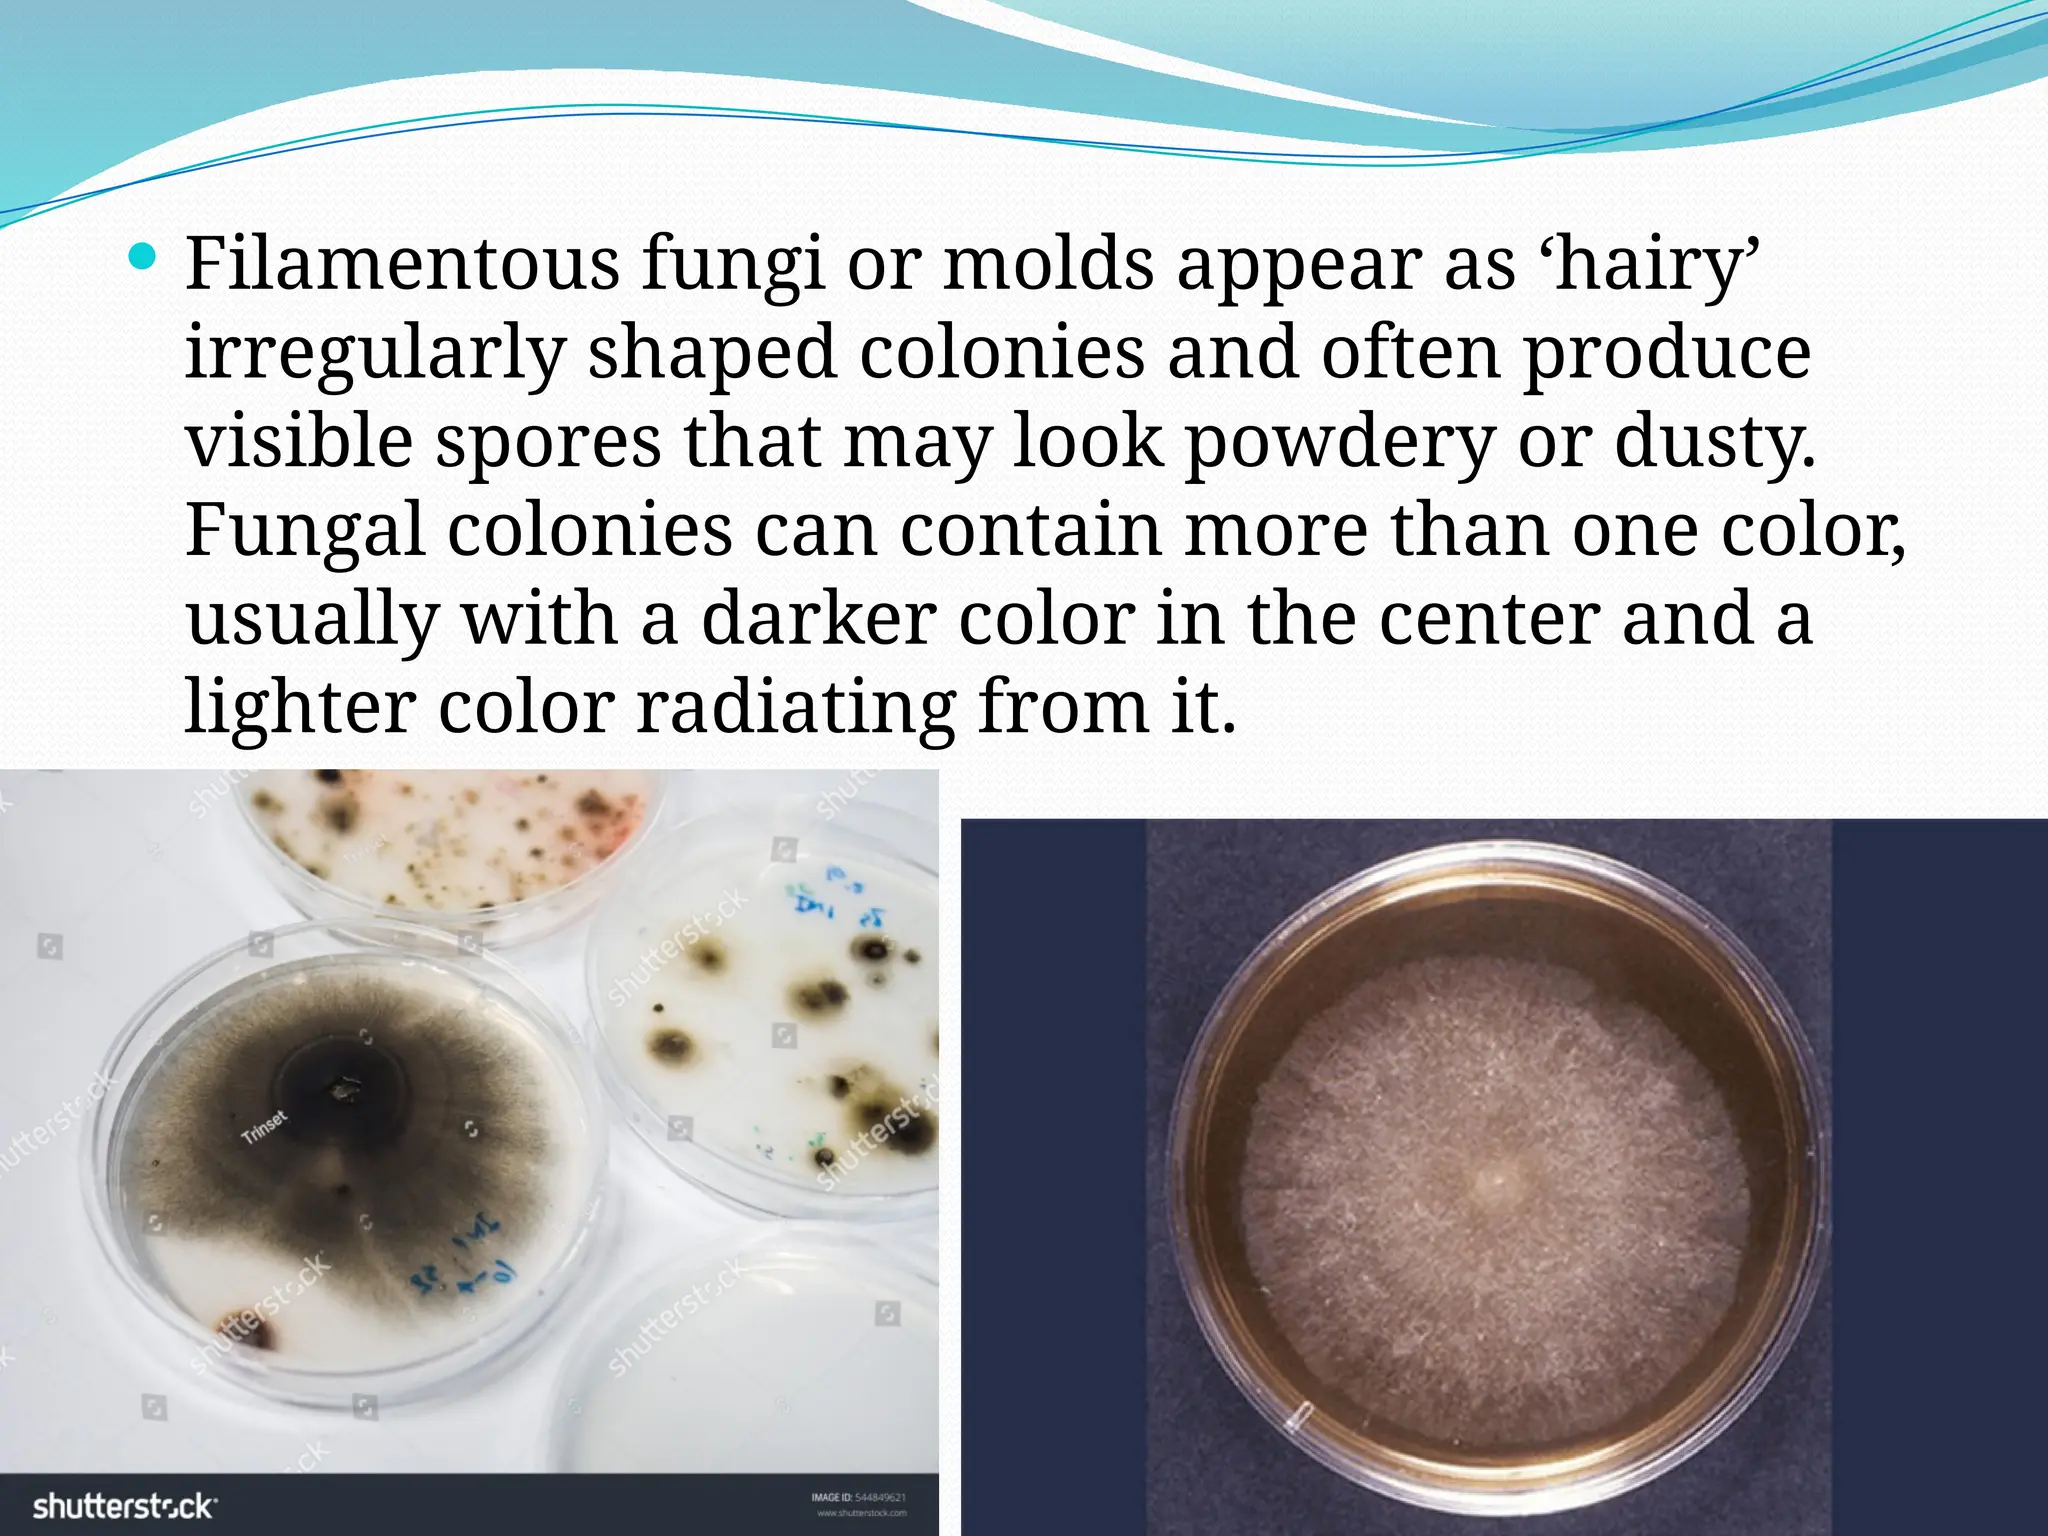
 Filamentous fungi or molds appear as ‘hairy’
irregularly shaped colonies and often produce
visible spores that may look powdery or dusty.
Fungal colonies can contain more than one color,
usually with a darker color in the center and a
lighter color radiating from it.
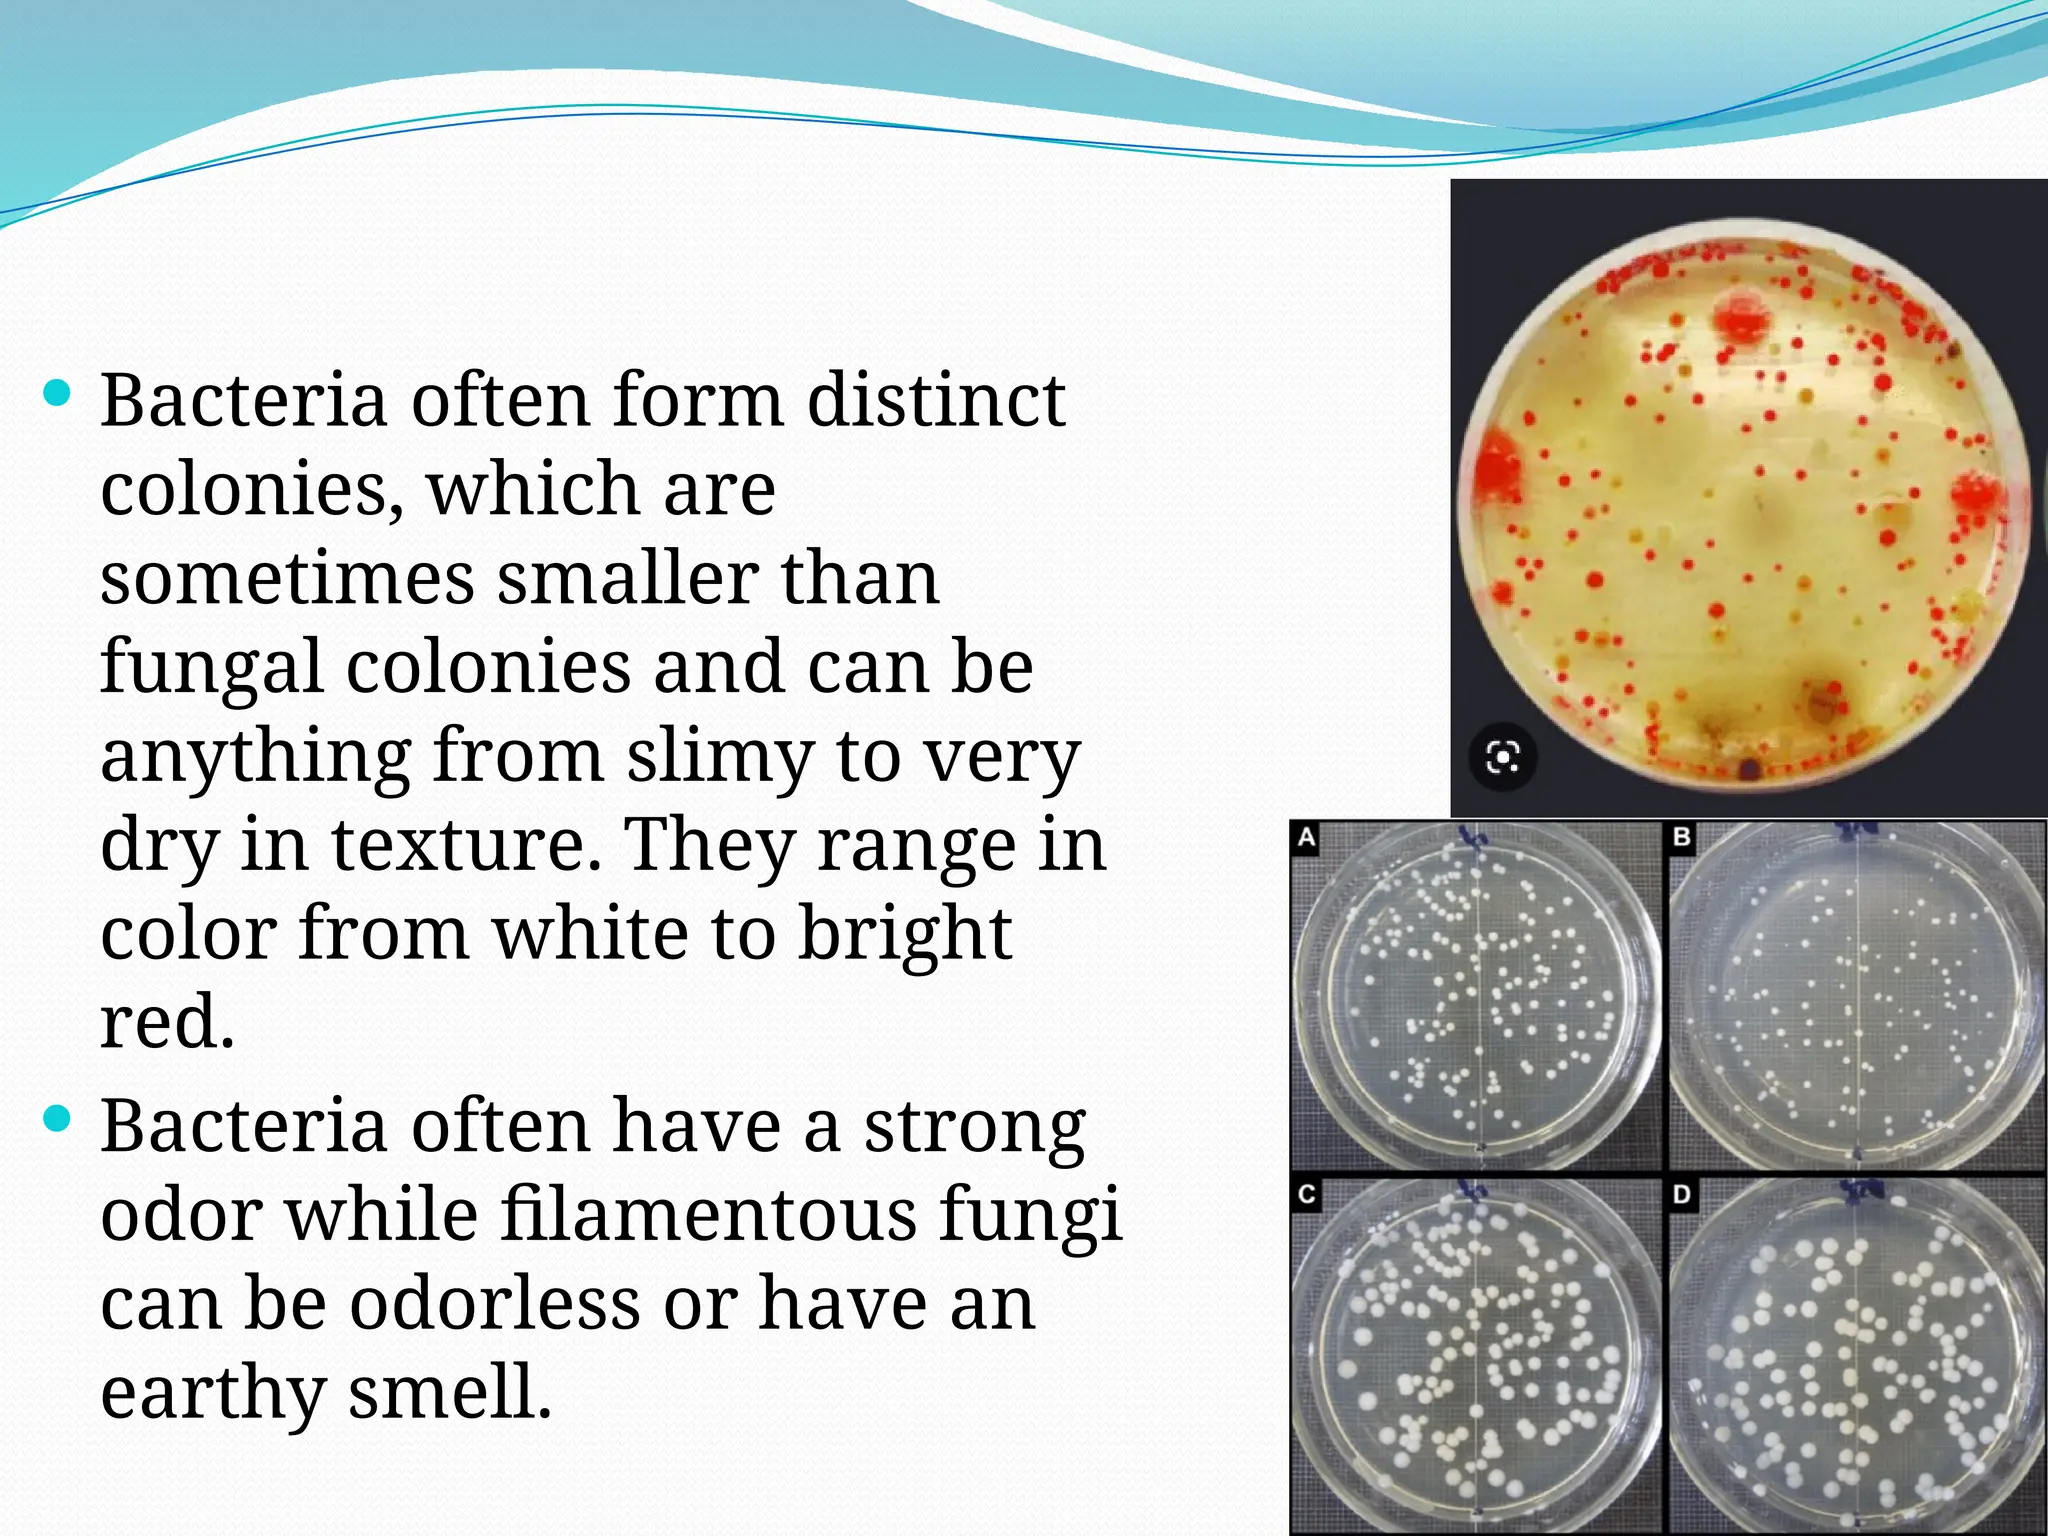
 Bacteria often form distinct
colonies, which are
sometimes smaller than
fungal colonies and can be
anything from slimy to very
dry in texture. They range in
color from white to bright
red.
 Bacteria often have a strong
odor while filamentous fungi
can be odorless or have an
earthy smell.

IDENTIFICATION OF MICROORGANISMS
**Methods for identifying microbes
1. Macroscopic Features
2. Staining and Microscopy (Gram staining, Endospore staining, Ziehl-Neelsen Staining, Stains for Fungi and Yeast)
3. Simple Biochemical Tests (Catalase Testing, Oxidase Testing)
4. Identifying Microbes Using PCR
5. Immunological Identification